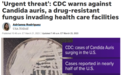
美国出现“超级真菌”!CDC发警告:正在以惊人速度传播,超一半患者在90天内死亡

美国当地时间3月20日,美国疾病控制预防中心(CDC)发布紧急通知:一种名为“耳念珠菌”(Candida Auris)的“超级真菌”正以惊人的速度在传播,现已有超过半数州报告病例。
CDC称,该病菌耐药性强,致死率高,约为30%-60%,近一半感染耳念珠菌(C. Auris)的患者会在90天内死亡!对老年人和免疫系统受损的人来说尤其危险。
同时也表示,如果你身体健康对“超级真菌”的传播也不必过分担心。
01“超级真菌”在美以惊人速度在传播
除感染人数不断膨胀,耳念珠菌遍及的地域也越来越广。
截止至去年12月,全美已有超过一半的州报告耳念珠菌(C. Auris)感染病例感染病例,其中内华达州、加州和佛罗里达州报告的感染人数最多。
图片来源于CDC官网。
研究表明,导致耳念珠菌(C. Auris)感染病例增加的原因有很多,特别是在2019年至2021年间,新冠疫情压力下,美国医疗机构很难采取有力措施阻断该病菌不断传播。
CDC报告称,耳念珠菌(C. Auris)通常不会对健康人构成威胁,但患重病、接受侵入性医疗设备治疗、以及长期或频繁在医疗保健机构住院的人群感染风险较大。该病毒可引发严重的侵入性感染,包括血液感染、伤口感染和耳部感染等。
研究表明,耳念珠菌对多种抗真菌药物具有耐药性,容易在医疗保健机构中传播,且死亡率较高。
近一半感染耳念珠菌(C. Auris)的患者会在90天内死亡,且感染者中有30%-60%死亡率。
数据截取自CDC官网。
真菌性疾病分部的医务人员莱曼(Meghan Lyman)表示,他们并不确定有多少病故可以直接归因于真菌,因为感染者通常还面临着其他多种健康威胁。耳念珠菌(C. Auris)既可能直接导致死亡,也可能与其他健康问题一同加速患者身体状况恶化。
CDC研究人员在美国知名医学期刊《内科医学年鉴》(Annals of Internal Medicine. Equally)发表这项研究,主要分析了耳念珠菌(C. Auris)近年来在美国的传播和感染状况。
据悉,美国于2016年发现首例耳念珠菌(C. Auris)感染病例,截至2021年12月31日,共报告了3,270例临床病例(其中存在感染)和7,413例筛查病例(其中检测到真菌但未导致感染)。其中2020至2021年在医疗保健机构以“惊人速度”传播。自2019年至2021年,已有17个州报告确诊病例。
数据截取自CDC官网。
在全美范围内,临床病例从2019年的476例上升到2021年的1,471例。从2020年到2021年,筛查病例数增加了两倍,共计4,041例。筛查对于通过识别携带真菌的患者来防止传播是非常重要的,可以预防并控制感染。
数据截取自CDC官网。
UMass Amherst微生物实验室教学服务主任汉伊利卡·哈密尔顿(Erika Hamilton)教授表示,“正常人感染该真菌的可能性很小,但是免疫力低下或住院的人则不同。感染的人已经病入膏肓,当你已经病入膏肓时,很难确定你感染了什么。”
“一旦耳念珠菌(C. Auris)进入血液,就很难被发现,然后导致全身感染。虽然通常真菌感染是可以治疗的,但耳念珠菌(C. Auris)能够抵抗多种可用的治疗方法。市场上没有那么多抗真菌药物,我们现有的抗真菌药物对这种特殊真菌的作用也不尽如人意,所以这真的很难治疗,”哈密尔顿(Hamilton)教授补充道。
“病例的快速上升和地域性传播令人担忧,应当强调监测重要性,扩大实验室能力,更快的诊断测试,并坚持行之有效的感染预防和控制,”CDC流行病学家梅根·莱曼(Meghan Lyman)教授说道。
02耳念珠菌传播、症状和预防
耳念珠菌(Candida Auris)是一种“超级真菌”且常见于院内感染,对于医院或疗养院内患有其他疾病的患者来说,“超级真菌”是一种可能致命的威胁。
耳念珠菌(C. Auris)进入人体后会随着血液扩散至全身,导致严重的侵袭性感染。而且,用标准的实验室方法很难鉴定,在没有特定技术的实验室里也可能被错误鉴定。错误识别可能导致治疗不及时。
耳念珠菌有怎样的感染症状?
耳念珠菌(Candida auris)感染症状可能因感染部位的不同而异,感染常常不易被诊断,因为其症状可能与其他感染或疾病相似。但常见的症状包括:
血液感染:发热、寒战、低血压、心跳过快、皮肤潮红等。
呼吸道感染:咳嗽、喉咙痛、气喘、呼吸困难等。
皮肤感染:皮肤瘙痒、红肿、疼痛、糜烂等。
耳朵感染:耳朵疼痛、耳垢增多、听力下降等。
泌尿生殖道感染:尿频、尿急、尿痛、阴道分泌物增多等。
耳念珠菌是如何进行传播的?
对于高危人群,如免疫力低下、长期住院的患者等,需要进行定期监测和预防性治疗。
直接接触:人与人之间的直接接触是最常见的传播途径。例如,接触已感染的皮肤、呼吸道或泌尿生殖道等部位的患者或携带者。
医疗设备: 耳念珠菌能够在医疗设备、如呼吸机、血液透析机、心脏起搏器、注射泵等上存活并繁殖,这些设备可能成为传播途径。
环境污染: 耳念珠菌能够在医疗环境中存活并扩散,包括医院的病床、座椅、空气、表面、水、餐具等。(该真菌可以在物体表面存活超过1个月的时间)
药物使用: 由于耳念珠菌的多重耐药性,药物使用不当可能导致感染的传播和加重。
图片来源Longbeach.gov,版权属于原作者
健康人群对于耳念珠菌的预防方法有哪些?
加强个人卫生:保持手部卫生,勤洗手,并在接触可能污染的表面后使用洗手液进行清洁。
避免接触已感染者:尽量避免接触已感染者的皮肤、呼吸道、泌尿生殖道等部位,并避免共用物品。
提高免疫力:通过保持良好的生活习惯、适当的运动和均衡的饮食等方式提高免疫力,从而预防感染。
图片来源于CDC官网。
由于耳念珠菌(C. Auris)极具耐药性,对常用的抗真菌药物没有反应,难以准确检测等多种特性,使得治疗更加复杂困难,因此及早发现和诊断十分重要。如果您有疑似耳念珠菌感染的症状,请及时就医,并告知医生您的病史和接触史,以便及早确定治疗方案。
美国疾病控制预防中心(CDC)指出,身体健康的公众对“超级真菌”的传播不必过分担心,医疗机构需警惕耳念珠菌(C. Auris)的传播。
如果你近期需要前往医院
建议做好防护和勤洗手!